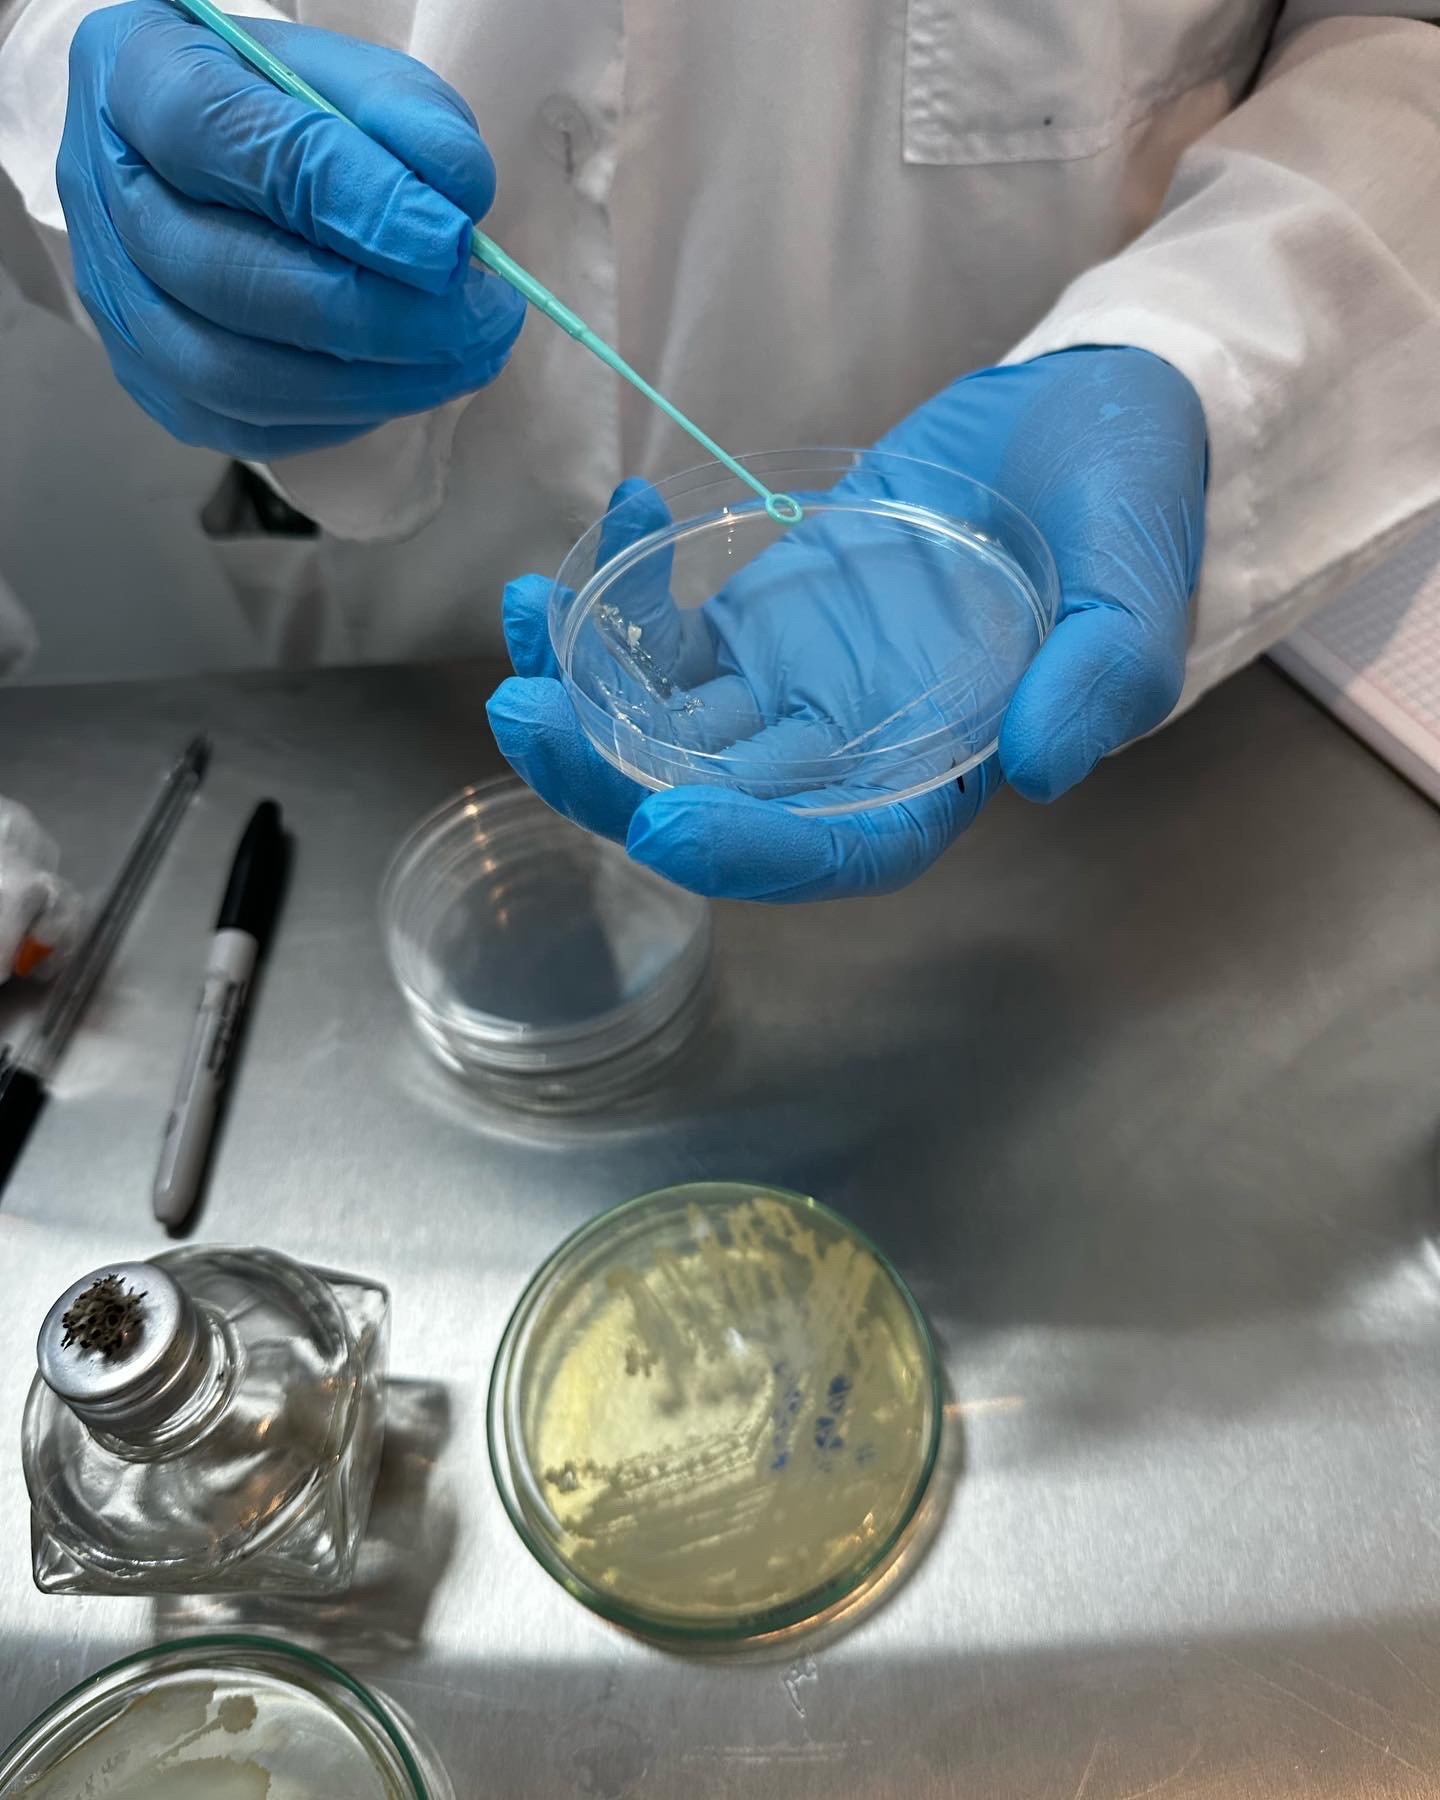

Planificación de Talleres Presenciales
En esta sección encontrarás la planificación oficial de los talleres presenciales que están siendo organizados próximamente en Ecuador. Aquí podrás revisar todos los detalles, contenidos, fechas, horarios, logística e información necesaria para tu proceso de inscripción.
Una vez que decidas participar, puedes comunicarte directamente al número de Atención al Cliente y Coordinación de Cursos: 098 031 7753, donde recibirás asistencia personalizada.
⚠️ Importante: Esta página está destinada exclusivamente a la información de talleres presenciales en Ecuador.